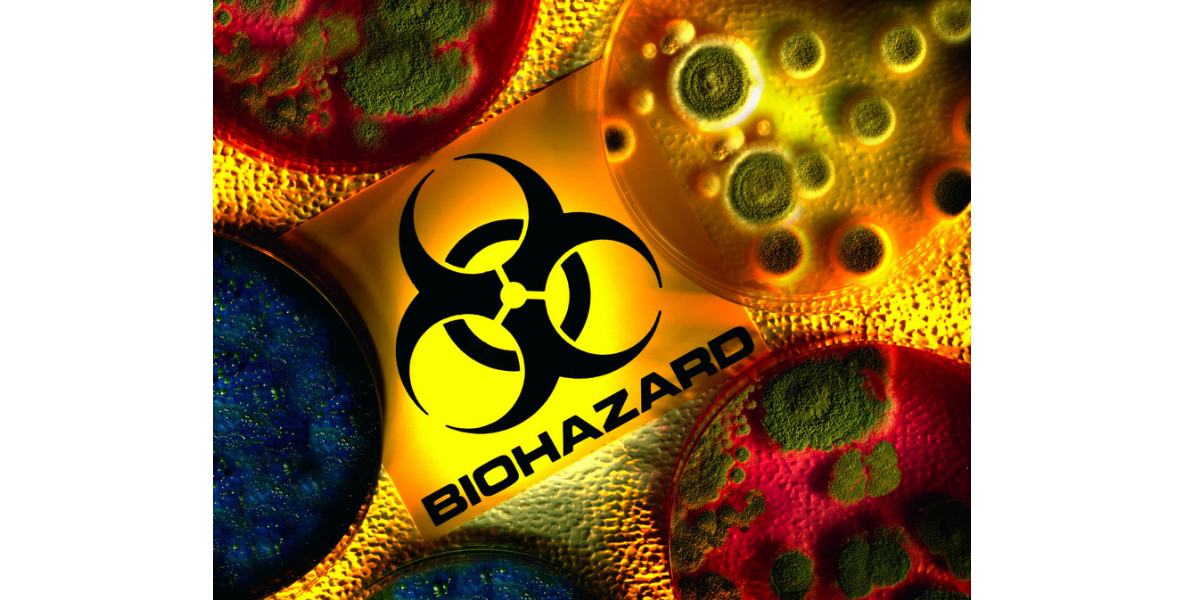

Property Restoration In The Pacific Northwest
Where Our Customers Are The H.E.A.R.T. Of Our Core Values
(503) 300-1006
Specializing In Mitigation, Content, and Reconstruction Services

CORE VALUES
Honesty & Integrity | Exacting Quality | Attentive Service | Respect | Tireless Communication
Northwest Restoration — Your One-Call Contractor for Property Damage Repairs
When fire, smoke, flooding, storms, or other forces damage your residential or commercial property, you need a contractor who can respond quickly with all the resources necessary to set things right.
If you are dealing with damage that requires restoration, it can be difficult to think of the next steps. That’s why when you work with us, we break everything down in a way that is easy to understand. Whenever you have questions, don’t hesitate to reach out to us. Spend some time navigating through the website so you can see all of the services that we have to offer. It’s better to tackle these problems sooner rather than later so that your property doesn't receive further damage. When you’re ready for water damage restoration in Salem, OR, Portland, OR, or Vancouver, WA, give us a call.
Northwest Restoration is truly one of the only full-service restoration contractors in Portland, Salem, Vancouver, and the surrounding areas that can deliver that level of service. We offer competitive pricing, and we can directly bill your insurance provider. Our work is warranted, and our company is locally and family-owned.
We also operate a full mitigation and contents facility located in Tualatin, OR, to handle content cleaning, storage, and restoration with the utmost care and efficiency. Call Northwest Restoration today for a fast response — we're available 24/7.
Specializing in Water, Fire, Smoke, Mold, and Storm Damage Restoration
Call Us First – You’ll Be Happy You Did
If it's not an emergency, please feel free to fill out our online form to request service.
Here's what our satisfied customers are saying...
24/7 Emergency Response Team
Call Northwest Restoration now!
Why Choose Northwest Restoration?
See why Northwest Restoration is the one that area homeowners and businesses rely on!
Certified by the IICRC (Institute of Inspection, Cleaning and Restoration Certification)
Over 35 years of combined experience in our management team
Licensed and certified for mold remediation and lead and asbestos abatement
Trained to safely clean and disinfect biohazards, odors, and COVID 19

Share On: